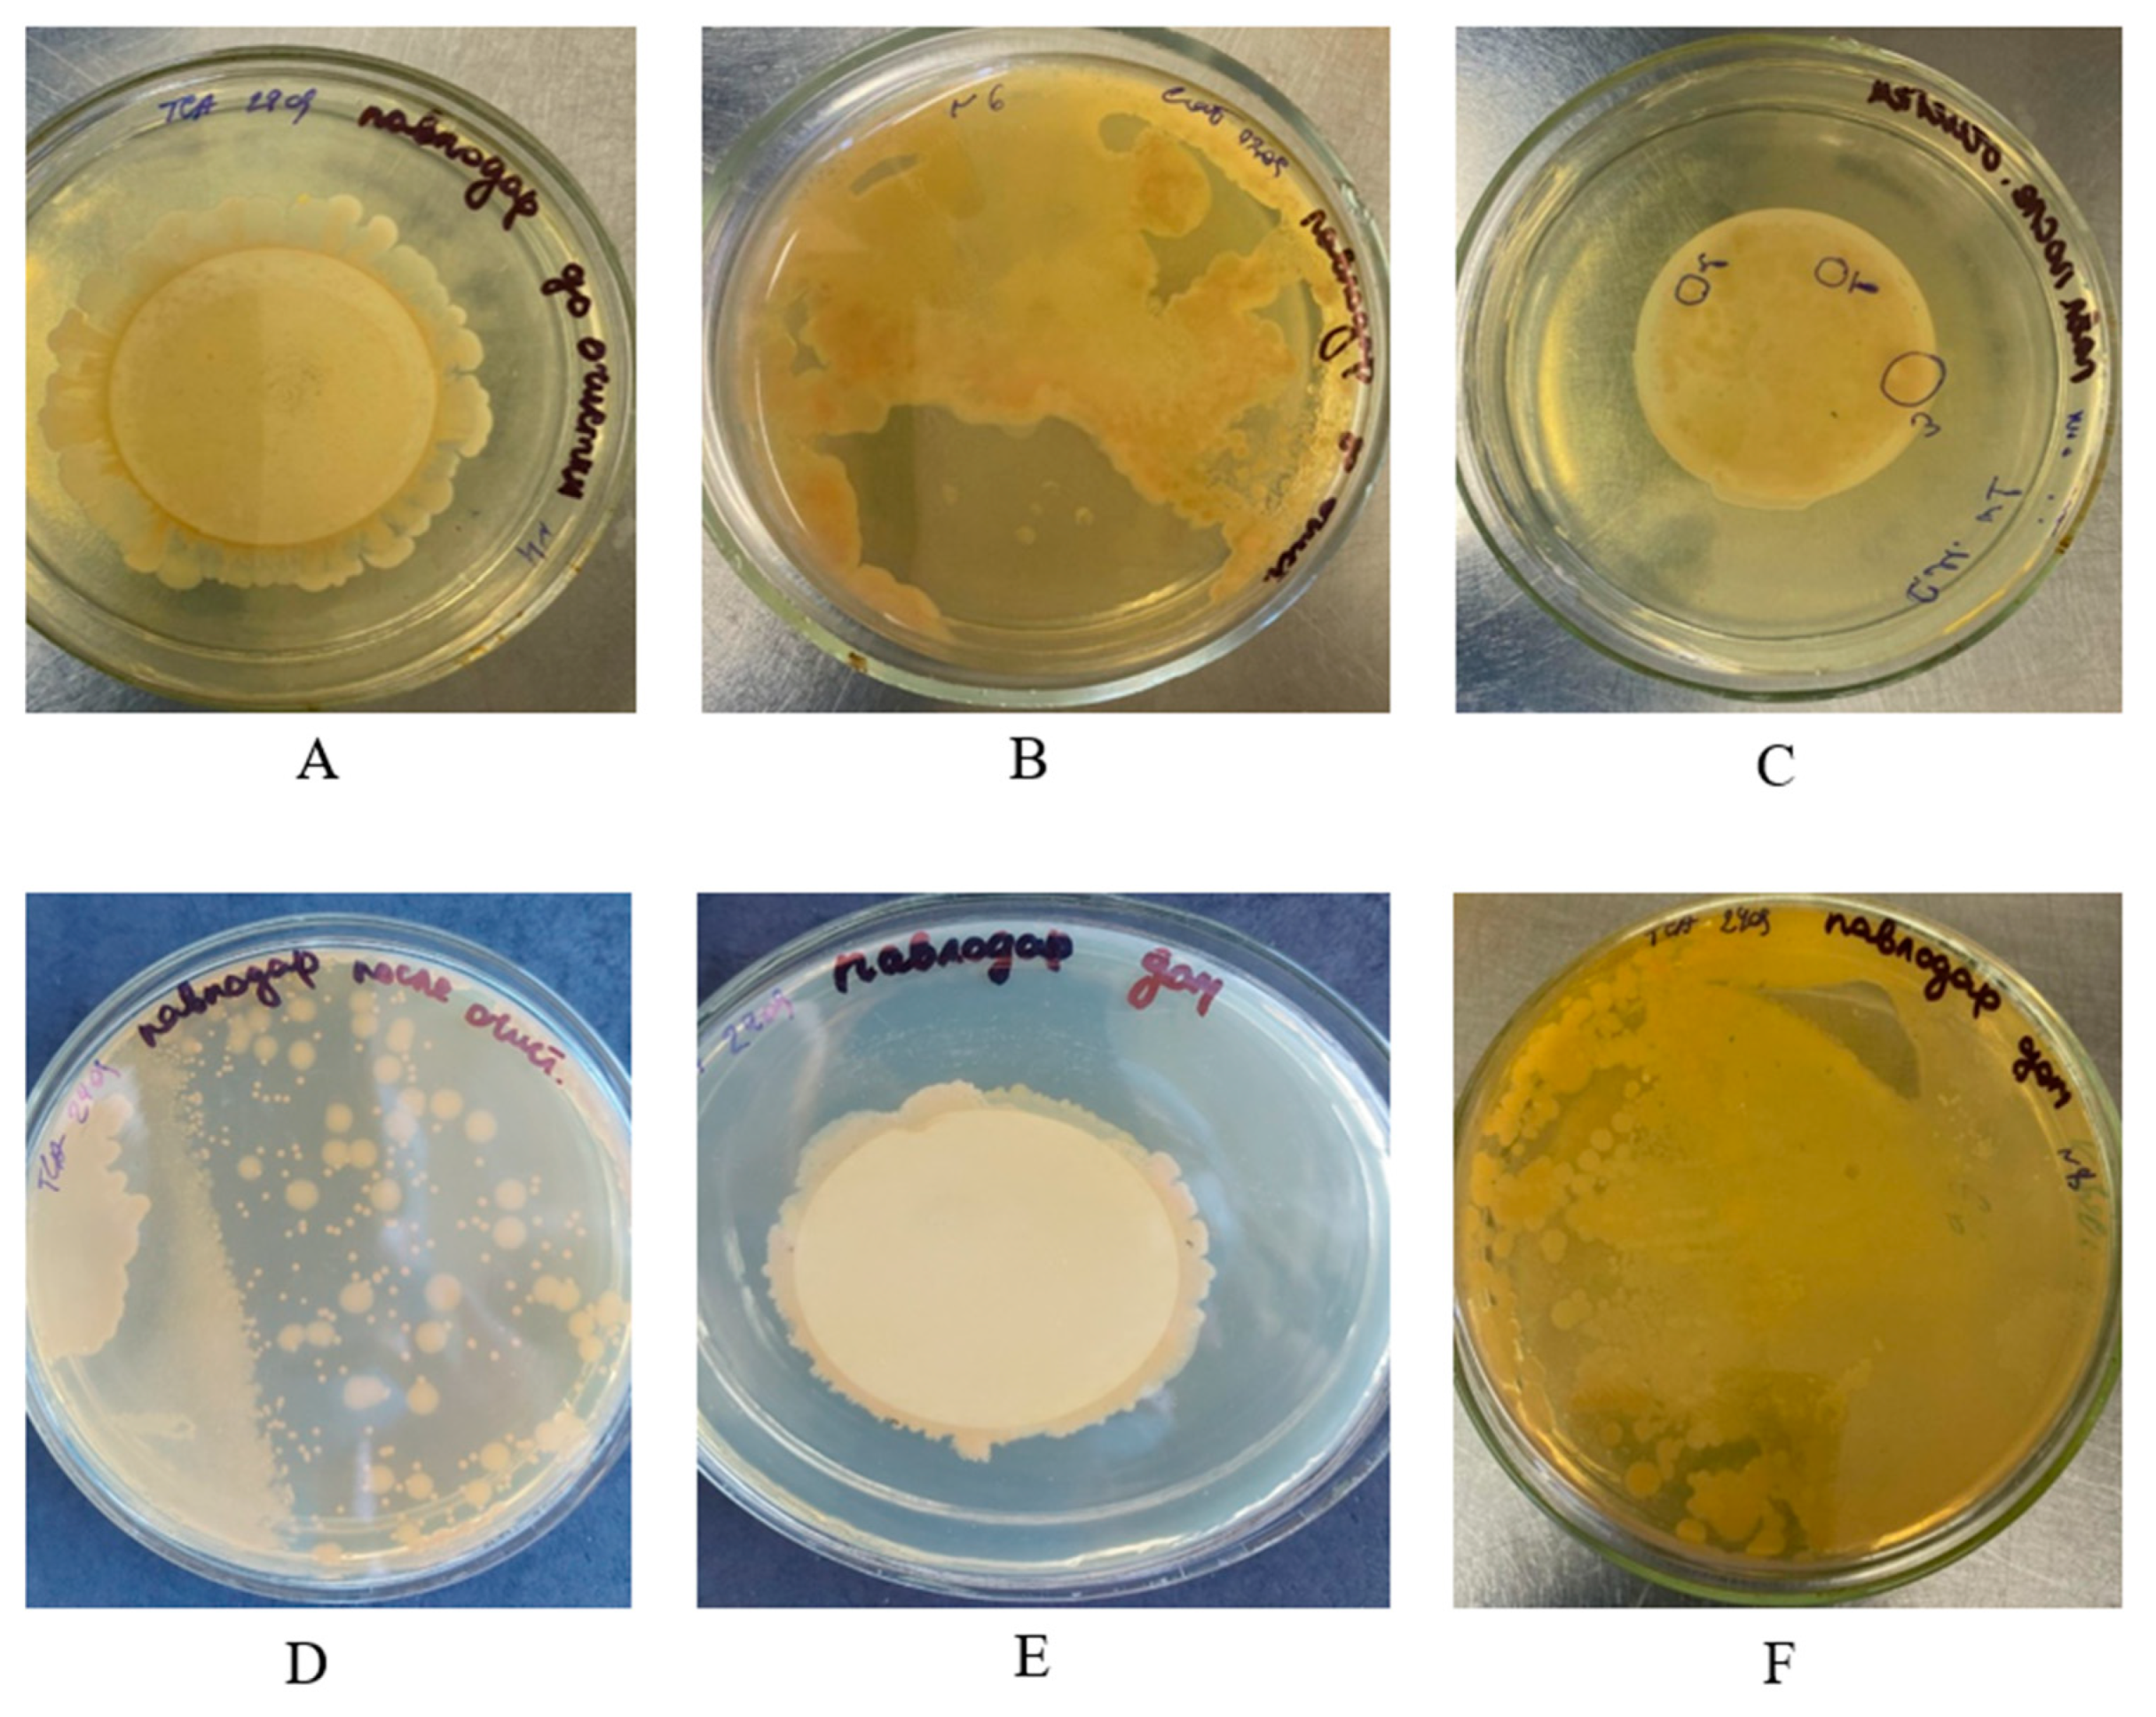
Water 16 02970 g003

Pathogen Contamination of Groundwater Affecting Drinking Water Quality with Potential Health Effects in Pavlodar Region, Kazakhstan
Abstract
1. Introduction
2. Materials and Methods
2.1. Sampling
2.2. General Drinking Water Indicators
2.3. Inorganic and Organic Substances
2.4. Microbiological Indicators
3. Results and Discussion
3.1. Microcomponent and Macrocomponent Analysis
3.2. Microbiological Analyses
4. Conclusions
Author Contributions
Funding
Data Availability Statement
Conflicts of Interest
Abbreviations
| CFU | Colony-forming unit |
| DDT | Dichlorodiphenyltrichloroethane |
| EU | European Union |
| GOST | State standards |
| MG | Methodological guidelines |
| MES | Recommended water quality standard of manganese |
| NGO | Non-governmental organization |
| OCB | Oxidase coliform bacteria |
| RK | Republic of Kazakhstan |
| TCA | Trichloroacetic acid |
| TCB | Thermotolerant coliform bacteria |
| TMC | Total microbial count |
| TSA | Tryptone soy agar |
| TTC | Triphenyltetrazolium chloride |
References
- Zektser, I.S.; Everett, L.G. Groundwater and the Environment; CRC Press, Taylor & Francis: London, UK, 2000; ISBN 978-0-367-80144-1. [Google Scholar]
- Chen, W.; Hou, Z.; Wu, L.; Liang, Y.; Wei, C. Evaluating salinity distribution in soil irrigated with saline water in arid regions of northwest China. Agric. Water Manag. 2010, 97, 2001–2008. [Google Scholar] [CrossRef]
- Micklin, P. The future Aral Sea: Hope and despair. Environ. Earth Sci. 2016, 75, 844. [Google Scholar] [CrossRef]
- Mukherjee, A.; Scanlon, B.R.; Aureli, A.; Langan, S.; Guo, H.; McKenzie, A.A. Global Groundwater: Source, Scarcity, Sustainability, Security, and Solutions; Elsevier: Amsterdam, The Netherlands, 2020. [Google Scholar] [CrossRef]
- Rosenberry, D.O.; Lewandowski, J.; Meinikmann, K.; Nützmann, G. Groundwater—The disregarded component in lake water and nutrient budgets. Part 1: Effects of groundwater on hydrology. Hydrol. Process. 2015, 29, 2895–2921. [Google Scholar] [CrossRef]
- Al-Katheeri, E.S. Towards the Establishment of Water Management in Abu Dhabi Emirate. Water Resour. Manag. 2008, 22, 205–215. [Google Scholar] [CrossRef]
- Tang, C.; Chen, J.; Shindo, S.; Sakura, Y.; Zhang, W.; Shen, Y. Assessment of groundwater contamination by nitrates associated with wastewater irrigation: A case study in Shijiazhuang region, China. Hydrol. Process. 2004, 18, 2303–2312. [Google Scholar] [CrossRef]
- Torkashvand, M.; Neshat, A.; Javadi, S.; Pradhan, B. New hybrid evolutionary algorithm for optimizing index-based groundwater vulnerability assessment method. J. Hydrol. 2021, 598, 126446. [Google Scholar] [CrossRef]
- Geng, C.; Lu, D.; Qian, J.; Xu, C.; Li, D.; Ou, J.; Ye, Z. A Review on Process-Based Groundwater Vulnerability Assessment Methods. Processes 2023, 11, 1610. [Google Scholar] [CrossRef]
- Adenova, D.; Sarsekova, D.; Absametov, M.; Murtazin, Y.; Sagin, J.; Trushel, L.; Miroshnichenko, O. The Study of Groundwater in the Zhambyl Region, Southern Kazakhstan, to Improve Sustainability. Sustainability 2024, 16, 4597. [Google Scholar] [CrossRef]
- Omarova, A.; Tussupova, K.; Hjorth, P.; Kalishev, M.; Dosmagambetova, R. Water Supply Challenges in Rural Areas: A Case Study from Central Kazakhstan. Int. J. Environ. Res. Public Health 2019, 16, 688. [Google Scholar] [CrossRef]
- Adenova, D.; Tazhiyev, S.; Sagin, J.; Absametov, M.; Murtazin, Y.; Trushel, L.; Miroshnichenko, O.; Zaryab, A. Groundwater Quality and Potential Health Risk in Zhambyl Region, Kazakhstan. Water 2023, 15, 482. [Google Scholar] [CrossRef]
- Machiwal, D.; Jha, M.K.; Singh, V.P.; Mohan, C. Assessment and mapping of groundwater vulnerability to pollution: Current status and challenges. Earth-Sci. Rev. 2018, 185, 901–927. [Google Scholar] [CrossRef]
- United Nations Economic Commission for Europe, The Protocol on Water and Health: A Framework for Action on Water, Sanitation, Hygiene and Health; United Nations: Erscheinungsort nicht ermittelbar. 2022; ISBN 978-92-1-001288-1. Available online: https://unece.org/sites/default/files/2022-01/ProtocolBrochure_E_ECE_MP.WH_21_WEB.pdf (accessed on 17 July 2024).
- Yang, D.; Ye, B.; Shiklomanov, A. Discharge Characteristics and Changes over the Ob River Watershed in Siberia. J. Hydrometeorol. 2004, 5, 595–610. [Google Scholar] [CrossRef]
- Tulendinova, Y.G.; Shvetsova, L.V. Altai State University (Barnaul, Russian Federation) Economic Use of Water Objects in the Territory of the Pavlodar Region of the Republic of Kazakhstan. In Proceedings of the Materialy IX Vserossijskoj s Mezhdunarodnym Uchastiem Nauchno-Prakticheskoj Konferencii “Prirodopol’zovanie i ohrana Prirody: Ohrana Pamjatnikov Prirody, Biologicheskogo i Landshaftnogo Raznoobrazija Tomskogo Priob’ja i Drugih Regionov Rossii”; Izdatel’stvo Tomskogo gosudarstvennogo universiteta, 2020; pp. 376–379. [Google Scholar] [CrossRef]
- Pavlodar Region Identifies Priority Sectors for Investments, Creates Favorable Conditions for Businesses with Access to Neighboring Markets—The Astana Times (In Russian). Available online: https://astanatimes.com/2021/05/pavlodar-region-identifies-priority-sectors-for-investments-creates-favorable-conditions-for-businesses-with-access-to-neighboring-markets/ (accessed on 20 February 2024).
- Climatic Conditions of the Pavlodar Region: Introduction as a Factor in Preserving the Biodiversity of Flora of the Pavlodar Region: Information, Timebiology.ru (In Russian). Available online: http://www.timebiology.ru/tmbls-1087-1.html (accessed on 20 February 2024).
- Zhupankhan, A.; Tussupova, K.; Berndtsson, R. Water in Kazakhstan, a Key in Central Asian Water Management. Hydrol. Sci. J. 2018, 63, 752–762. [Google Scholar] [CrossRef]
- Vinokurov, Y.I. Regional environmental problems in transboundary basins of Ural and Irtysh rivers. Proc. Russ. Acad. Sci. Geogr. Ser. 2010, 3, 95–104. [Google Scholar]
- Vinokurov, Y.I. (Ed.) Environmental Risks in the Transboundary Basin of the Irtysh River; SB RAS Publ.: Novosibirsk, Russia; Sibirskoe otdelenie RAN: Novosibirsk, Russia, 2014; ISBN 978-5-7692-1335-9. [Google Scholar]
- Baikenova, G.E.; Baranovskaya, N.V.; Bersimbaev, R.I.; Kakabayev, A.A.; Tulindinova, G.K.; Toktaganova, G.B. Elemental Composition of Salt Sediments of Drinking Water in Northern Kazakhstan (the Case of Akmola and Northern Kazakhstan Regions). Eurasian J. Ecol. 2021, 66. [Google Scholar] [CrossRef]
- Arynova, S.Z.; Rikhvanov, L.P. Ecological and geochemical assessment of the territory of the Pavlodar region (Republic of Kazakhstan) according to the study of the elemental composition of salt deposits of drinking waters. Bulletin 2015, 12, 4–10. [Google Scholar]
- Inglezakis, V.J.; Azat, S.; Tauanov, Z.; Mikhalovsky, S.V. Functionalization of biosourced silica and surface reactions with mercury in aqueous solutions. Chem. Eng. J. 2021, 423, 129745. [Google Scholar] [CrossRef]
- Azhayev, G.; Esimova, D.; Sonko, S.M.; Safarov, R.; Shomanova, Z.; Sambou, A. Geoecological environmental evaluation of Pavlodar region of the Republic of Kazakhstan as a factor of perspectives for touristic activity. Geoj. Tour. Geosites 2020, 28, 104–113. [Google Scholar] [CrossRef]
- Tussupova, K.; Hjorth, P.; Berndtsson, R. Access to Drinking Water and Sanitation in Rural Kazakhstan. Int. J. Environ. Res. Public Health 2016, 13, 1115. [Google Scholar] [CrossRef]
- United Nations Economic Commission for Europe. HABITAT III Regional Report on Housing and URBAN Development for the UNECE Region: Towards a City-Focused, People-Centred and Integrated Approach to the New Urban Agenda. 2016. Available online: https://unece.org/fileadmin/DAM/hlm/sessions/docs2015/informal_notes/3_HABITAT_III_Regional_Report.pdf (accessed on 17 July 2024).
- Asian Development Bank, Astana Integrated Water Master Plan: Technical Assistance Completion Report. 2022. Available online: https://www.adb.org/projects/documents/kaz-51353-001-tcr (accessed on 17 July 2024).
- Bekturganov, Z.; Tussupova, K.; Berndtsson, R.; Sharapatova, N.; Aryngazin, K.; Zhanasova, M. Water Related Health Problems in Central Asia—A Review. Water 2016, 8, 219. [Google Scholar] [CrossRef]
- Water Quality Observations in the May Group Water Supply System in Pavlodar Region (In Russian). Available online: https://www.inform.kz/ru/kachestvo-vody-proverili-v-mayskom-gruppovom-vodoprovode-v-pavlodarskoy-oblasti_a3777869 (accessed on 21 July 2024).
- Lei, Y.; Deng, M.; Li, X.; Zhang, Y.; Long, A. Analysis of Water Resources Development in Kazakhstan. In Proceedings of the 2012 International Symposium on Geomatics for Integrated Water Resource Management; IEEE: Lanzhou, China, 2012; pp. 1–6. Available online: https://ieeexplore.ieee.org/document/6349620 (accessed on 21 February 2024).
- Hrkal, Z.; Gadalia, A.; Rigaudiere, P. Will the river Irtysh survive the year 2030? Impact of long-term unsuitable land use and water management of the upper stretch of the river catchment (North Kazakhstan). Environ. Geol. 2006, 50, 717–723. [Google Scholar] [CrossRef]
- Abdiyev, K.; Azat, S.; Kuldeyev, E.; Ybyraiymkul, D.; Kabdrakhmanova, S.; Berndtsson, R.; Khalkhabai, B.; Kabdrakhmanova, A.; Sultakhan, S. Review of Slow Sand Filtration for Raw Water Treatment with Potential Application in Less-Developed Countries. Water 2023, 15, 2007. [Google Scholar] [CrossRef]
- Radelyuk, I.; Tussupova, K.; Persson, M.; Zhapargazinova, K.; Yelubay, M. Assessment of groundwater safety surrounding contaminated water storage sites using multivariate statistical analysis and Heckman selection model: A case study of Kazakhstan. Environ. Geochem. Health 2021, 43, 1029–1050. [Google Scholar] [CrossRef]
- Ministry of Health, Kazakhstan, Decree: On approval of the Sanitary Rules ‘Sanitary and Epidemiological Requirements for Water Sources, Places of Water Intake for Household and Drinking Purposes, Household and Drinking Water Supply and Places of Cultural and Domestic Water Use and the Safety of Water Bodies’—IPS ‘Adilet’ (In Russian). February 20, 2023, no. 26. Available online: https://adilet.zan.kz/rus/docs/V2300031934/history (accessed on 21 February 2024).
- Alimbaev, T.; Khassenova, Z.; Zhalmurzina, A. The Environmental State of the Pavlodar Region in the Republic of Kazakhstan (1990s). E3S Web Conf. 2024, 510, 03034. [Google Scholar] [CrossRef]
- ST RK ISO 5667-6-2017; Water Quality—Sampling—Part 6. KazInMetr: Astana, Kazakhstan, 2017.
- GOST 26449.1-85; Stationary Distillation Desalting Units. Methods of Saline Water Chemical Analysis. Publishing House of Standards: Moscow, Russia, 1985.
- GOST 4151-72; Drinking Water. Method for Determination of Total Hardness. Publishing House of Standards: Moscow, Russia, 1972.
- ST RK GOST R 51211-2003; Method for Analysis of Surfactants. KazInMetr: Astana, Kazakhstan, 2003.
- KZ.07.00.01340-2016; Method for Analysis of Phenolic Index. KazInMetr: Astana, Kazakhstan, 2016.
- KZ.07.00.01147-2015; Method for Analysis of Boron Content. KazInMetr: Astana, Kazakhstan, 2015.
- GOST 3351-74; Method for Analysis of Organoleptic Substances. Publishing House of Standards: Moscow, Russia, 1974.
- GOST 31868-2012; Method for Analysis of Organoleptic Substances. Rosstandart: Moscow, Russia, 2012.
- GOST 18165-2014; Method for Analysis of Inorganic Substances. Rosstandart: Moscow, Russia, 2014.
- GOST 33045-2014; Method for Analysis of Inorganic Substances. Rosstandart: Moscow, Russia, 2014.
- GOST 18294-89; Method for Analysis of Inorganic Substances. Publishing House of Standards: Moscow, Russia, 1989.
- СТ РК 452-2002; Method for Analysis of Inorganic Substances. KazInMetr: Astana, Kazakhstan, 2002.
- GOST 4011-72; Method for Analysis of Iron. Publishing House of Standards: Moscow, Russia, 1972.
- GOST 26449.2-85; Method for Analysis of Potassium by Flame Photometry. Publishing House of Standards: Moscow, Russia, 1985.
- ST RK ISO 8288-2005; Method for Analysis of Metal Concentrations by Flame Atomic Adsorption. KazInMetr: Astana, Kazakhstan, 2005.
- GOST 4386-89; Method for Analysis of Cupper by Extraction-Photo Colometry. Publishing House of Standards: Moscow, Russia, 1989.
- GOST 31870-2012; Method for Analysis of Metal Concentration by Atomic-Emission Spectrometry with Inductively Coupled Plasma. Rosstandart: Moscow, Russia, 2012.
- GOST 4245-72; Method for Analysis of Chloride Content by Titrimetric Method. Publishing House of Standards: Moscow, Russia, 1972.
- ST RK GOST R 51209-2003; Method for Analysis of DDT Isomers by Gas–Liquid Chromatography Method with Electron Capture Detector. KazInMetr: Astana, Kazakhstan, 2003.
- World Health Organization. Guidelines for Drinking-Water Quality: Fourth Edition Incorporating First Addendum; 4th ed + 1st add.; World Health Organization: Geneva, Switzerland, 2017; ISBN 978-92-4-154995-0. Available online: https://www.who.int/publications/i/item/9789241549950 (accessed on 17 July 2024).
- Microorganisms, Toxins and Epidemics, 2nd ed.—Website of Mikhail Vasilievich Supotnitsky (In Russian). Available online: https://www.supotnitskiy.ru/book/book1-1.htm (accessed on 21 February 2024).
- Khan, A.A.; Cerniglia, C.E. Detection of Pseudomonas aeruginosa from clinical and environmental samples by amplification of the exotoxin A gene using PCR. Appl. Environ. Microbiol. 1994, 60, 3739–3745. [Google Scholar] [CrossRef]
- Nurtazin, S.; Pueppke, S.; Ospan, T.; Mukhitdinov, A.; Elebessov, T. Quality of Drinking Water in the Balkhash District of Kazakhstan’s Almaty Region. Water 2020, 12, 392. [Google Scholar] [CrossRef]
- Abdullaev, I.; Rakhmatullaev, S. Transformation of water management in Central Asia: From State-centric, hydraulic mission to socio-political control. Environ. Earth Sci. 2015, 73, 849–861. [Google Scholar] [CrossRef]
- Tussupova, K.; Berndtsson, R.; Bramryd, T.; Beisenova, R. Investigating Willingness to Pay to Improve Water Supply Services: Application of Contingent Valuation Method. Water 2015, 7, 3024–3039. [Google Scholar] [CrossRef]
- Sailaukhanuly, Y.; Popova, A.; Mansur, T.; Bexeitova, K.; Azat, S.; Toshtay, K.; Tovassarov, A.; Tasmagambetova, A. Preliminary Study and Assessment of Drinking Water from Almaty, Kazakhstan. Eurasian Chem. J. 2022, 24, 341–350. [Google Scholar] [CrossRef]
- Pozdnyakova, A.P.; Taizhanova, D.Z.; Guseinova, Z.K.; Turemuratova, D.T.; Ashirbekov, G.K. Creening of the health status of the population in the territories, approaching to the district of «Proton-M» Accident in 2013, and in the comparison area-Aiteke Bi 1SPE «SRC «Karysh-Ecology» (Almaty, Republic of Kazakhstan). Med. Ecol. 2018, 1, 47–52. [Google Scholar]
- Philipp, J. Healthcare in Kazakhstan: Problems and Solutions. The Borgen Project 2020. Available online: https://borgenproject.org/healthcare-in-kazakhstan/ (accessed on 17 July 2024).

| No. | Name and Coding of Nutrient Media and Reagents | Manufacturer | Characteristics |
|---|---|---|---|
| 1 | Standard TTC-NKS nutrient carton plates | Dr. Moller-Schmelz, Göttingen, Germany | Sterile |
| 2 | Endo agar (M029) | HiMedia, Mumbai, India | pН (25 °C) 7.4 ± 0.2 |
| 3 | Tryptone soy agar (M290) | HiMedia, Mumbai, India | рН (25 °C) 7.4 ± 0.2 |
| 4 | Water | - | Sterile |
| 5 | Ethanol | Talgar Spirit (ethanol), Astana, Kazakhstan | 96% |
| 6 | NEFERM test | MIKROLATEST, Brno, Czech Cat. No.: MLT00010 | - |
| 7 | Clostridium agar | HiMedia, Mumbai, India | рН (25 °C) 7.4 ± 0.2 |
| 8 | Oxidase discs | HiMedia, Mumbai, India | - |
| 9 | Hydrogen peroxide-DF 100 mL solution | Dospharm, Almaty, Kazakhstan | 3.0% |
| Media | Temperature | Incubation Time |
|---|---|---|
| Standard TTC substrates | 37 ± 1 °C | 5 days |
| Endo agar | 37 ± 1 °C | 18–48 h |
| Endo agar | 43 ± 1 °C | 18–48 h |
| Tryptone soy agar | 37 ± 1 °C | 18–24 h |
| Medium for clostridia | 37 ± 1 °C | 18–24 h |
| Indicator | Water Sample | Standard * [32] | ||
|---|---|---|---|---|
| W1 | W2 | W3 | ||
| Smell, score | 0 | 0 | 0 | ≤2 |
| Chromaticity, degree | 0 | 0 | 0 | ≤20 (35) |
| Turbidity, mg/L (kaolin) | 3.5 | 0 | 0 | ≤1.5 |
| Indicator | Water Sample | Standard ** [32] | ||
|---|---|---|---|---|
| W1 | W2 | W3 | ||
| pH | 7.15 | 7.75 | 7.42 | Within 6–9 |
| Total mineralization | 429 | 423 | 405 | ≤1000 (1500) |
| 290 | 278 | 278 | ||
| Dry residue, mg/L | 4.1 | 4.03 | 3.7 | ≤7.0 (10) |
| Total hardness, mmol/L | 0.004 | 0.002 | 0.002 | * n.d. (0.1) |
| Total petroleum products, mg/L | * n.d. (0.05) | * n.d. (0.05) | * n.d. (0.05) | * n.d. (0.5) |
| Surfactants, mg/L | * n.d. (0.0001) | * n.d. (0.0001) | * n.d. (0.0001) | * n.d. (0.25) |
| Indicator | Water Sample | Standard ** [32] | ||
|---|---|---|---|---|
| W1 | W2 | W3 | ||
| γ- Hexachlorocyclohexane (lindane) | * n.d. (0.0001) | * n.d. (0.0001) | * n.d. (0.0001) | ≤0.002 |
| DDT (sum of isomers) | * n.d. (0.0001) | * n.d. (0.0001) | * n.d. (0.0001) | ≤0.002 |
| 2,4-D | * n.d. (0.0005) | * n.d. (0.0005) | * n.d. (0.0005) | ≤0.03 |
| Aluminum (Al3+), mg/L | * n.d. (0.04) | * n.d. (0.04) | * n.d. (0.04) | ≤0.5 |
| Ammonia (by nitrogen), mg/L | * n.d. (0.05) | * n.d. (0.05) | * n.d. (0.05) | ≤2.0 |
| Beryllium (Be2+), mg/L | * n.d. (0.0002) | * n.d. (0.0002) | * n.d. (0.0002) | ≤0.0002 |
| Boron (B, total), mg/L | * n.d. (0.01) | * n.d. (0.01) | * n.d. (0.01) | ≤0.5 |
| Hydrocarbonates (HCO3), mg/L | 256.3 | 250.2 | 238.0 | Not regulated |
| Iron (Fe, total), mg/L | * n.d. (0.05) | * n.d. (0.05) | * n.d. (0.05) | ≤0.3 (1.0) |
| Potassium (K+), mg/L | 2.0 | 1.6 | 1.9 | Not regulated |
| Carbonate (CO32−), mg/L | * n.d. (8.0) | * n.d. (8.0) | * n.d. (8.0) | Not regulated |
| Calcium (Ca2+), mg/L | 66.1 | 65.1 | 60.1 | Not regulated |
| Cadmium (Cd, total), mg/L | * n.d. (0.01) | * n.d. (0.01) | * n.d. (0.01) | ≤0.001 |
| Cobalt (Co), mg/L | 0.0008 | 0.0006 | 0.0006 | ≤0.1 |
| Silicon (Si), mg/L | 8.6 | 8.6 | 8.4 | ≤10 |
| Lithium (Li+), mg/L | * n.d. (0.01) | * n.d. (0.01) | * n.d. (0.01) | ≤0.03 |
| Magnesium (Mg2+) | 9.7 | 9.4 | 8.5 | Not regulated |
| Manganese (Mn), mg/L | 1.69 | 0.006 | 0.017 | ≤0.1 (0.5) |
| Copper (Cu), mg/L | 0.001 | 0.004 | 0.008 | ≤1.0 |
| Molybdenum (Mo), mg/L | 0.002 | 0.001 | 0.001 | ≤0.25 |
| Arsenic (As), mg/L | 0.0015 | 0.0015 | 0.0019 | ≤0.05 |
| Sodium (Na+), mg/L | 31.1 | 31.0 | 30.3 | ≤200.0 |
| Nickel (Ni), mg/L | 0.003 | 0.005 | 0.006 | ≤0.1 |
| Nitrates (NO3−), mg/L | * n.d. (0.2) | * n.d. (0.2) | * n.d. (0.2) | ≤45 |
| Nitrite (NO2−), mg/L | * n.d. (0.005) | * n.d. (0.005) | * n.d. (0.005) | ≤3.0 |
| Mercury (Hg), mg/L | * n.d. (0.0001) | * n.d. (0.0001) | * n.d. (0.0001) | ≤0.0005 |
| Lead (Pb), mg/L | 0.0002 | * n.d. (0.01) | 0.0003 | ≤0.03 |
| Selenium (Se), mg/L | * n.d. (0.0002) | * n.d. (0.0002) | * n.d. (0.0002) | ≤0.01 |
| Silver (Ag), mg/L | * n.d. (0.01) | * n.d. (0.01) | 0.0001 | ≤0.05 |
| Strontium (Sr2+), mg/L | 0.3 | 0.3 | 0.3 | ≤7.0 |
| Sulfate (SO42−), mg/L | 40.3 | 41.2 | 42.0 | ≤500 |
| Chloride (Cl−), mg/L | 14.9 | 15.6 | 15.6 | ≤350 |
| Chromium (Cr), mg/L | 0.002 | 0.002 | 0.002 | ≤0.5 |
| Cyanide (CN−), mg/L | * n.d. (0.005) | * n.d. (0.005) | * n.d. (0.005) | ≤0.035 |
| Zinc (Zn2+), mg/L | * n.d. (0.01) | * n.d. (0.01) | * n.d. (0.01) | ≤5.0 |
| Indicator | Water Sample | Regulatory Document [32] | |||||
|---|---|---|---|---|---|---|---|
| W1, M ± StD | W1, CV, % | W2, M ± StD | W2, CV, % | W3, M ± StD | W3, CV, % | ||
| Total microbial count, CFU/mL | 1198.3 ± 13.5 | 1.13 | 331.3 ± 25.5 | 7.7 | 616.0 ± 24.0 | 3.9 | ≤50 |
| Total coliform bacteria, CFU/100 mL | * n.d. | * n.d. | * n.d. | * n.d. | * n.d. | * n.d. | * n.d. |
| Coliform thermotolerant bacteria, CFU/100 mL | * n.d. | * n.d. | * n.d. | * n.d. | * n.d. | * n.d. | * n.d. |
| Sulfite-reducing clostridium spores, number of spores in 20 mL | * n.d. | * n.d. | * n.d. | * n.d. | * n.d. | * n.d. | * n.d. |
| Water Sample | Test Method | |||
|---|---|---|---|---|
| Oxidase Test | Catalase Activity Test | NEFERM Test, % | Tinctorial Properties | |
| W1 | + | + | Pseudomonas aeruginosa—99.4 | Bacillus spp., Sarcina spp. |
| W2 | + | + | Pseudomonas aeruginosa—99.4 | Bacillus spp. |
| W3 | + | + | Pseudomonas aeruginosa—99.4 | Bacillus spp. |
| Pseudomonas monteilii—81.0 | ||||
Disclaimer/Publisher’s Note: The statements, opinions and data contained in all publications are solely those of the individual author(s) and contributor(s) and not of MDPI and/or the editor(s). MDPI and/or the editor(s) disclaim responsibility for any injury to people or property resulting from any ideas, methods, instructions or products referred to in the content. |
© 2024 by the authors. Licensee MDPI, Basel, Switzerland. This article is an open access article distributed under the terms and conditions of the Creative Commons Attribution (CC BY) license (https://creativecommons.org/licenses/by/4.0/).
Share and Cite
Azat, S.; Kuldeyev, E.; Khalkhabay, B.; Baikadamova, A.; Sultakhan, S.; Berndtsson, R. Pathogen Contamination of Groundwater Affecting Drinking Water Quality with Potential Health Effects in Pavlodar Region, Kazakhstan. Water 2024, 16, 2970. https://doi.org/10.3390/w16202970
Azat S, Kuldeyev E, Khalkhabay B, Baikadamova A, Sultakhan S, Berndtsson R. Pathogen Contamination of Groundwater Affecting Drinking Water Quality with Potential Health Effects in Pavlodar Region, Kazakhstan. Water. 2024; 16(20):2970. https://doi.org/10.3390/w16202970
Chicago/Turabian StyleAzat, Seitkhan, Erzhan Kuldeyev, Bostandyk Khalkhabay, Ainur Baikadamova, Shynggyskhan Sultakhan, and Ronny Berndtsson. 2024. "Pathogen Contamination of Groundwater Affecting Drinking Water Quality with Potential Health Effects in Pavlodar Region, Kazakhstan" Water 16, no. 20: 2970. https://doi.org/10.3390/w16202970
APA StyleAzat, S., Kuldeyev, E., Khalkhabay, B., Baikadamova, A., Sultakhan, S., & Berndtsson, R. (2024). Pathogen Contamination of Groundwater Affecting Drinking Water Quality with Potential Health Effects in Pavlodar Region, Kazakhstan. Water, 16(20), 2970. https://doi.org/10.3390/w16202970

